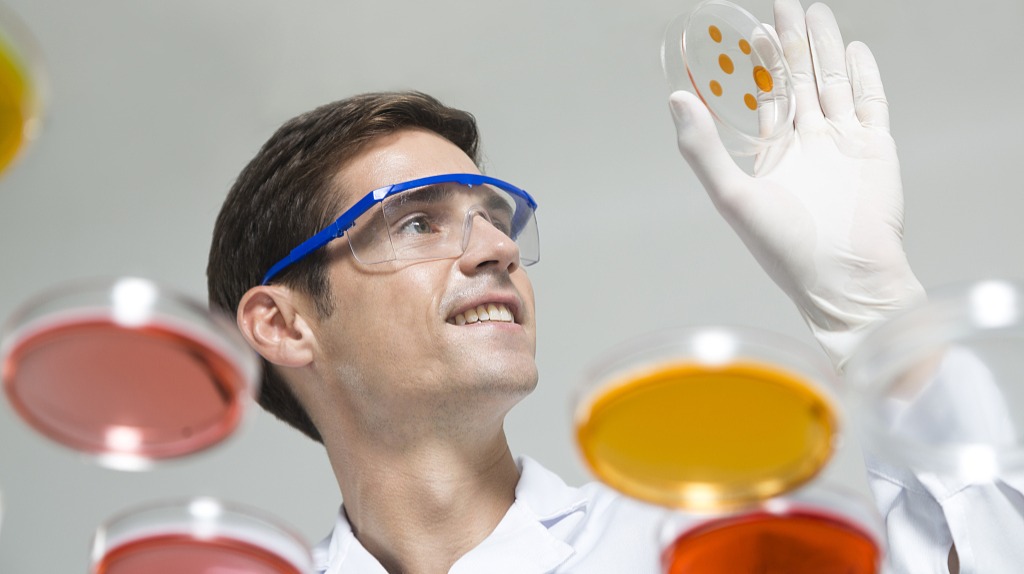

本文来自微信公众号:果壳(Guokr42),作者:Sheldon,对白、美指:牛猫,封面:视觉中国
感到缺氧时,人体细胞就会分泌一种激素,让身体多生产点儿红细胞,尽快恢复氧气的供应。
可见,缺氧并不可怕,因为人体细胞能够探测氧气的浓度,并随时作出反应。
那么,人体细胞又是怎么做到的呢?
美国医学家格雷格·塞门扎和英国医学家彼得·拉特克利夫发现,这是因为在人体细胞中,有一种懂得垃圾分类的细胞因子,叫作缺氧诱导因子-1α(HIF-1α)。
他们发现,如果氧气浓度太低,缺氧诱导因子-1α就会进入细胞核,给相关的基因通报情况,让细胞赶紧做出反应。
那么,当人体不缺氧时,缺氧诱导因子-1α又在做什么呢?
它完全不发挥作用,因为它被人体当作垃圾分解掉了。
这又是怎么回事呢?
美国医学家小威廉·凯林和彼得·拉特克利夫陆续发现,
这是因为在人体细胞中,还有一帮分子在默默地搞垃圾分类。当人体不缺氧时,氧气和一种叫作VHL的分子,会将缺氧诱导因子-1α,标记成了“易腐垃圾”。于是,细胞就会把它分解掉,防止人体过度反应。
这种缺氧保护机制十分重要。正常细胞固然离不开它,但癌细胞更加离不开它!
科学家推测,如果用药物打破癌细胞的缺氧保护,就有可能抑制癌细胞的生长,甚至杀死癌细胞!
注:这些药物研究仍在进行中,请不要相信非专业人员的虚假宣传。
为了表彰他们发现细胞感知和适应环境含氧量的相关机制,诺奖委员会授予小威廉·凯林、彼得·拉特克利夫和格雷格·塞门扎2019诺贝尔生理学奖或医学奖!
注:1.缺氧诱导因子-1α进入细胞核后,需要先与另一种叫作ARNT的分子结合,形成一种蛋白复合物,然后才能发挥激活相关基因的作用。
2. 除了癌细胞之外,缺氧保护还与很多人体疾病有关。
本文首发于腾讯新闻账号@果壳,本页刊发内容未经书面许可禁止转载及使用,媒体、报刊等转载请联系公众号果壳(ID:Guokr42)
如对本稿件有异议或投诉,请联系 tougao@huxiu.com。